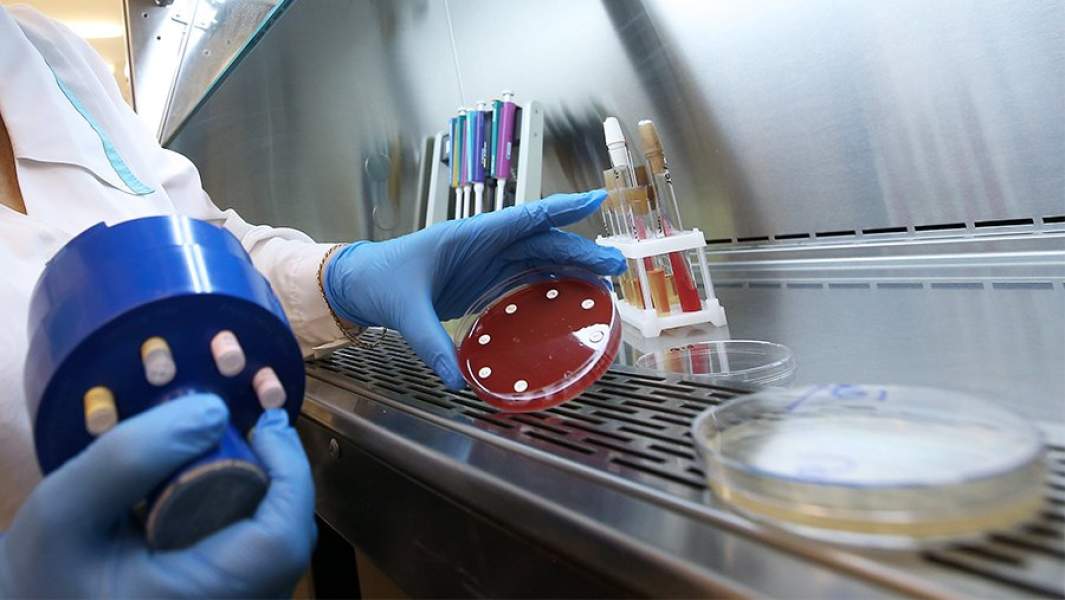
Тест

ВИЧный вопрос: пациенты пожаловались на нехватку препаратов в колониях

Заключенные с ВИЧ пожаловались на нехватку необходимых лекарств, сообщили «Известиям» представители общественного движения «Пациентский контроль». Там получили обращения из исправительных колоний в семи российских регионах, больше всего — от пациентов из Самарской области. Во ФСИН России «Известиям» сообщили, что информация общественников не соответствует действительности и запас препаратов достаточен. При этом, согласно открытым данным госзакупок, в 2022 году для уголовно-исполнительной системы закуплено на 17,8% меньше средств от ВИЧ, чем годом ранее.
Просьбы о помощи
Пациенты с ВИЧ, находящиеся в местах заключения, сообщили о нехватке препаратов — такие сигналы поступили из семи российских регионов. Жалобы собирает общественное движение «Пациентский контроль» (объединение людей, живущих с ВИЧ и другими социально значимыми заболеваниями). Сообщения, с которыми ознакомились «Известия», передают по просьбе пациентов их родственники и знакомые. Согласно им, необходимые лекарства заканчиваются, а некоторые и совсем закончились в ряде колоний в Волгоградской, Ленинградской, Нижегородской, Новосибирской, Ростовской, Самарской и Свердловской областях.
«Закончились почти все препараты. Врач выдает то, что есть, но скоро и это закончится. Терапию и лечение нельзя прерывать даже на незначительное время. Это может привести к трагическим и необратимым последствиям и летальному исходу», — передал жалобу сын осужденной женщины, отбывающей наказание в Самарской области.
«У моей жены ВИЧ-положительный статус, она не получает терапию, так как ее нет в колонии, и когда она будет, неизвестно, — сообщил муж осужденной из этого же региона. — Помогите, пожалуйста. Людям, сидящим там, очень нужна терапия».
«Мужу не выдают таблетки. Сказали, что их нет в наличии, и на замену непонятно что дадут», — пишет супруга одного из заключенных, отбывающего наказание в Ростовской области.
Из Волгоградской области передают, что там часто меняют схемы лечения — то есть заменяют подобранный ранее пациенту набор таблеток на другой. На это же жалуются и из Самарской области.
Замена препаратов
Обычно к новым препаратам пациенты адаптируются несколько месяцев — процесс может сопровождаться головокружением, тошнотой и другими неприятными ощущениями. При этом бросать или прерывать прием своей схемы нельзя — в таких случаях возникает резистентность, то есть организм перестает реагировать на эти препараты, в результате схему приходится вновь менять и вновь переживать период адаптации.
О такой ситуации предупреждает мать одного из осужденных из Волгоградской области: «В последний месяц ему даже назначили «Карсил» (препарат для улучшения функции печени. — «Известия») в таблетках из-за осложнений с печенью, вызванных постоянным прерыванием терапии от ВИЧ».
В движении «Пациентский контроль» уверены, что полученные из колоний сообщения — «это только часть верхушки айсберга».
— Пациенты зачастую не жалуются на перебои с лечением, опасаясь, что могут ухудшить свои отношения с персоналом колонии, получат выговор, будут помещены в штрафной изолятор или подвергнутся другим санкциям, — рассказала «Известиям» активистка «Пациентского контроля» Юлия Верещагина.
При этом особо критической она назвала ситуацию в колониях Самарской области, отмечая, что жалобы на нехватку препаратов оттуда были и в прошлом году.
Как следует из сообщений, перебои возникли с препаратами атазанавир, долутегравир, рилпивирин+тенофовир+эмтрицитабин (три препарата в одной таблетке), ритонавир, лопинавир+ритонавир, дарунавир.
ФСИН опровергает
Движение «Пациентский контроль» обратилось к руководству Минздрава и ФСИН, сообщив о жалобах и перечислив регионы и исправительные учреждения, из которых они поступали. В обращении отмечается, что «выдача неполных схем лечения или прерывание лечения ВИЧ-инфекции может привести к развитию резистентных форм вируса, прогрессированию болезни, ухудшению состояния здоровья пациентов, увеличению смертности, в том числе за счет развития ВИЧ-ассоциированных заболеваний».
Во ФСИН России дефицит лекарств отрицают.
— Информация о нехватке препаратов для лечения ВИЧ-инфицированных лиц, содержащихся в учреждениях уголовно-исполнительной системы, указанных в вашем запросе, не соответствует действительности, — сообщили «Известиям» в пресс-службе ведомства.
Там указали, что «запас лекарственных препаратов в учреждении достаточный и позволяет обеспечить необходимым лечением пациентов с ВИЧ-инфекцией».
В пресс-службе Минздрава в ответ на запрос «Известий» сообщили, что потребность для ФСИН была утверждена в октябре 2022 года и закупки проводятся «в соответствии с планом-графиком».
— Для бесперебойного обеспечения пациентов на ряд лекарственных препаратов уже заключены долгосрочные контракты, — рассказали в Минздраве. — При необходимости имеется возможность перераспределения лекарственных препаратов между субъектами России, учреждениями Федерального медико-биологического агентства и ФСИН.
Но какова была заявленная потребность ФСИН на 2023 год, сколько было закуплено препаратов в прошлом году и сколько мог составить остаток на начало года, в ведомстве не сообщили.
Федеральный центр планирования и организации лекарственного обеспечения граждан Минздрава России в своем ответе движению «Пациентский контроль» (документ есть в распоряжении «Известий») также сообщил, что по состоянию на 28 февраля 2023 года учреждения ФСИН не размещали сообщения о нехватке лекарств от ВИЧ. Это следует из ежемесячного мониторинга остатков лекарств в регионах России.
По данным проекта «Коалиция по готовности к лечению» (занимается независимым мониторингом закупок препаратов от социально значимых болезней, анализирует открытые данные госзакупок), в 2020 году для ФСИН было закуплено 50 092 годовых курса препаратов, в 2021 году — 34 787, в 2022 году — 21 452. Дополнительно к этому в 2022 году из средств 2023 года был закуплен еще 7161 курс. Таким образом, общие закупки 2022 года составили 28 613 курсов (–17,75% по сравнению с предыдущим годом).
— Даже если сложить закупки ФСИН 2022 года и то, что закуплено в 2022-м на средства 2023 года, то получится всё равно меньше, чем в 2021 году, — констатировала руководитель отдела мониторинга коалиции Наталья Егорова.
При этом оценивать, насколько данные закупки закрывают потребность системы, Наталья Егорова не стала.
— Система ФСИН не идет на диалог с пациентским сообществом, и выяснить ситуацию досконально не представляется возможным, — сказала она.
В России лечение пациентов с ВИЧ полностью обеспечивается за счет государства. В 2021 году на закупку лекарств для них из федерального бюджета было направлено 27,28 млрд рублей (+2,88 млрд рублей по сравнению с 2020 годом), из них 1,36 млрд составили закупки для ФСИН. На 2022 и 2023 годы в госбюджете на эти цели было заложено по 31,7 млрд рублей.